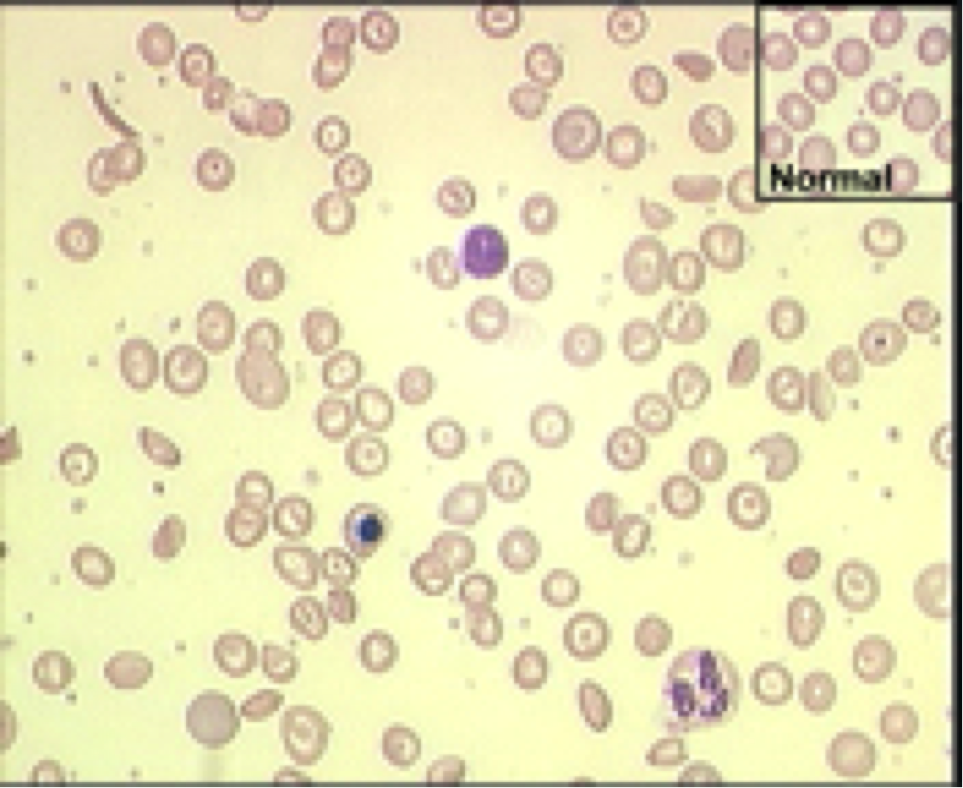

Define Hemoglobinopathy
- A genetic defect that results in abnormal structure of one of the globin chains of the hemoglobin molecule
- Very few actually produce a “disease” or disorder
- Most are asymptomatic abnormal hematologic findings
Pathophysiology, Hemoglobinopathies
(4 generals)
- Increased/ decreased O2 affinity
- Methemoglobinemia
- Unstable hemoglobin
- Sickling and crystallization
Sickling and Crystallization
(2 responsible hemogobins and their genetic mutations)
Both single amino acid substitutions!
•Hemoglobin S - substitution of valine for glutamic acid
•Hemoglobin C - substitution of lysine for glutamic acid
Laboratory Tools for Hemoglobinopathy Dx (4)
•CBC
•Peripheral blood smear
•Hemoglobin separation
–Electrophoresis
–HPLC (High Performance Liquid Chromatography)
–Isoelectric focusing
•Sickle cell screening
Hemoglobin Electrophoresis
(function, general MOA)
•Used to isolate, identify, and quanititate hemoglobin bands (reported in % of each Hgb type)
•When placed in an electrical field, hemoglobins will migrate according to their
–pH
–Media used
A2 comigrates c Hgb C. This picture was not completely acurate

Sickle Cell Screening
(2 tests)
- Solubility Test (not entirely useful)
- Hemoglobin Electrophoresis (NYS requires this for formal dx)
Sickle Solubility Test
(definition, explaination, interpretation)
Definition - Sickling hemoglobin in a deoxygenated state will precipitate in a concentrated phosphate buffer solution
Explaination - Abnormal band in S position. Since there are multiple sickled cells that migrate c hgb S, this separates it out
Interpretation - If you can see the lines its negative

Sickle Solubility Test Procedure Notes
(4)
•Not specific for Hgb S
•Cannot resolve trait vs disease
•False pos with increased proteins, hyperlipidemia, high WBC, cold reagents
•Sensitivity approx 20-25%
–Infants
–Transfusions
- These are screened in NY newborns
- *Solubility test isn’t good for this - lack of sensitivity in terms of hemoglobin type and hemoglobin S concentration *
- Lots of false positives due to prep
Hemoglobin S and Sickle Cell Disease Epidemiology and Genetics
(2 different groups)
•Incidence in African populations is 40%
•Incidence in African-Americans is 8%
-Established itself as a protective mechanism against malaria
Pathophysiology, Hemoglobin S and Sickle Cell Disease
(4)
- Under low oxygen tension, hemoglobin S will precipitate forming tactoids
- RBCs stretch around the tactoids, forming the characteristic sickled cells
- The greater the proportion of Hgb S, the greater the propensity to sickle
- Heterozygotes do not sickle except under extraordinary conditions
Clinical Findings, Sickle Cell Disease
•Vaso-occlusion
–dactylitis - swollen and painful feet
–auto-splenectomy
–renal necrosis
–infarctive crisis
–leg ulcers
–infection
•Chronic hemolysis
–anemia
–jaundice
–cholelithiasis
–aplastic crisis
–hemolytic crisis (classic situation where cells sickle and BM reacts by making more RBCs that then sickle. This is bad)
Laboratory Findings, Sickle Cell Disease
(5)
–Severe normocytic, normochromic anemia
–Blood smear - target cells, sickle cells, nRBC, schistocytes, siderotic granules, Howell-Jolly bodies
–Reticulocytes increased, except in aplastic crisis
–Hemoglobin electrophoresis - Hgb S = 80-90%, Hgb F = 1-20%, Hgb A2 = 2-3%
–Sickle test - positive
Laboratory Findings, Sickle Cell Trait
(4)
–normal CBC
–normal blood smear
–Hemoglobin electrophoresis - Hgb A = 55-65%, Hgb S = 35-45%, Hgb A2 = 2-3%
–Sickle test - positive
Identify Pathology

Sickle Cell (probably disease)
Note the pointed corners

Identify Pathology
Nucleated RBCs, BM’s response to sickle cell anemia crisis
Thalassemia
(define, classification system)
- Inherited disorder caused by gene mutations or deletions that reduce or eliminate the synthesis of one or more globin chains of the hemoglobin tetramer
- Leads to defective hemoglobin production and damage to the RBC
- Named according to the globin chain that is deficient
Globin Chain Synthesis Evolution c Age
See attached. Note, this is a normal representation
- 2 alpha + 2 gama = Hgb F
- 2 alpha + 2 delta = Hgb A2
- 2 alpha + 2 beta = Hgb A

Genetic Ctrl of Hb Synthesis
(List 2 chromosomes and which globin chains are coded there)
- Chromosome 16 - all 4 alpha alleles
- Chromosome 11 - Gama, delta, and beta alleles
Categories of Thalassemia
•Beta-thalassemia
–Beta0 - no beta chains produced
–Beta+ - decreased beta chains produced
•10 - 50% normal beta chain synthesis
•Alpha-thalassemia
Geographical Distribution, Beta Thalassemias
The highest frequencies of beta thalassemia occur in the Mediterranean countries (Greece and Italy), the Arabian Peninsula, Turkey, Iran, Africa, India, Southeast Asia, and southern China.
Geographic Distribution, Alpha Thalassemias
- Alpha thalassemia’s geographical distribution is similar to that of beta thalassemia. The single alpha globin gene deletion(-a/aa) is prevalent across tropical Africa, the Mediterranean region, the Middle East, India, Southeast Asia, and southern China.
- Alpha thalassemia trait in cis presentation (–/aa) is generally, but not exclusively, limited to individuals whose ancestry is of Southeast Asian, southern Chinese, or rarely Mediterranean origin.
Pathophysiology, Thalassemias
•Imbalance of globin chain synthesis
- Lack of hgb — small, hypochromic cells
•Ineffective erythropoiesis
- Excess unpaired hgb chains precipitate in cell causing membrane damage
•Cells destroyed in marrow or spleen

Genetic Defects
(name 4, their MOAs)
- Single nucleotide or point mutation
- Decreased amount of RNA
- Base substitutions
- Alter promoter function, RNA processing or translation
- Insertion or deletion mutations
- Create frameshifts that prevent normal globin synthesis
- Large deletion
- Removes one or more genes
Clinical Syndromes of the Thalassemias
(3)
- Beta- thalassemia minor
- heterozygous
- Beta- thalassemia major
- homozygous
- Beta- thalassemia intermedia
- intermediate symptoms
- Combination of double heteroxygous parents






